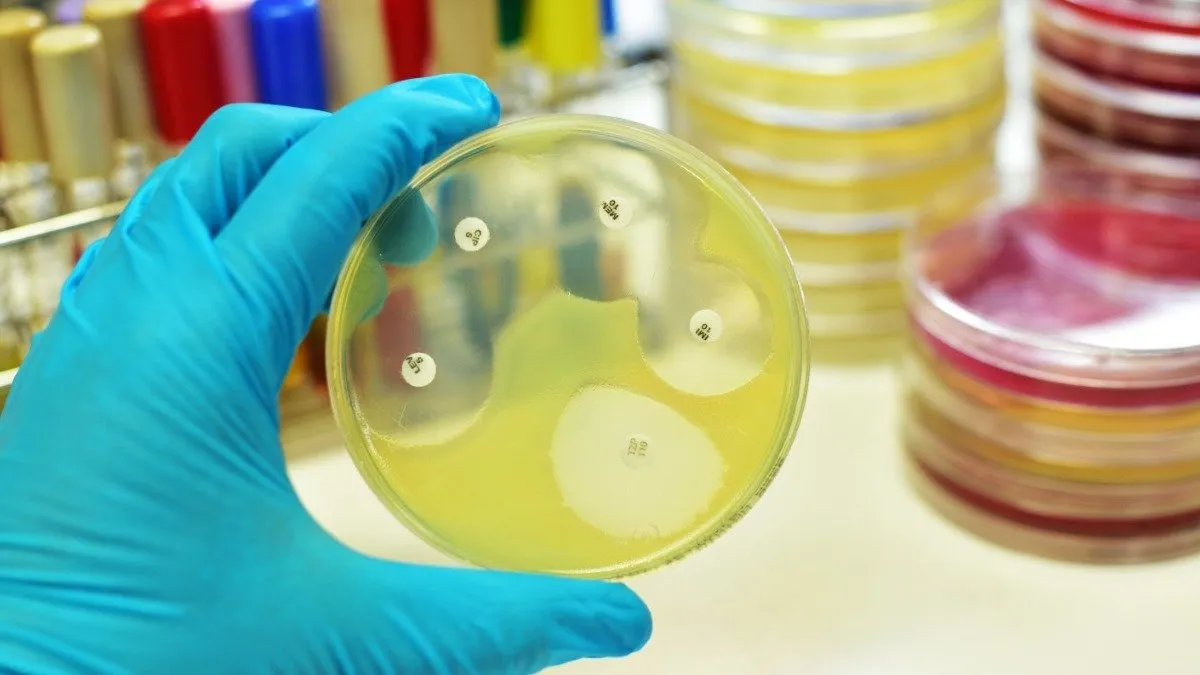

Para 2050, unos 10 millones de personas podrían morir en todo el mundo cada año a causa de la resistencia a antimicrobianos o antibiótica (AMR, por sus siglas en inglés). El alarmante problema podría significar que la próxima pandemia está llegando en silencio, de acuerdo a la Organización de Naciones Unidas (ONU).
MILLONES DE MUERTES
Antimicrobianos: La próxima pandemia está llegando en silencio
Hasta 10 millones de muertes podrían ocurrir cada año hacia el 2050 debido a la resistencia a los antimicrobianos, advirtió la ONU.
Se estima que las cepas de bacterias resistentes a los antibióticos, llamadas superbacterias, fueron la causa de fallecimiento de 1,27 millones de personas en 2019. De hecho, la Organización Mundial de la Salud (OMS) la reconoce como una de las principales amenazas para la salud global a corto plazo.
Tales cifras fueron presentadas en el en el Sexto Encuentro Global de Líderes de Grupo de la AMR el martes pasado (7 de febrero) en Barbados, basadas en el informe 'Preparándose para las superbacterias: Fortalecimiento de la acción ambiental en la respuesta de One Health a la resistencia a los antimicrobianos'.
La resistencia a los antimicrobianos es un fenómeno natural y aparece cuando los microorganismos mutan por la sobreexposición o mala exposición a los antibióticos, por lo que desarrollan la resistencia.
Como resultado, las medicinas se vuelven ineficaces, las infecciones persisten y el riesgo de contagio aumenta.
La clave del nuevo documento
El nuevo informe de la ONU hizo énfasis en la contaminación como un factor determinante en el "desarrollo, la transmisión y la propagación" de la resistencia a los antimicrobianos.
El uso excesivo y el mal uso de antibióticos en humanos, animales y plantas solo ha empeorado el problema.
Principalmente, hay tres sectores económicos impulsores del problema:
- Productos farmacéuticos y otros productos químicos.
- Agricultura y alimentos.
- Atención médica, junto con contaminantes provenientes de saneamiento deficiente, aguas residuales y efluentes de desechos en los sistemas municipales.
Un caso claro son los herbicidas que se usan para controlar las malas hierbas en el campo incrementan el peligro.
Lo que sucede es que, una vez que los antimicrobianos ingresan al medio ambiente, se filtran en la cadena alimentaria, en peces y ganado por ejemplo, y regresan a las fábricas en las que se elaboran artículos de cotidianos.
"Este es un problema real, porque los ríos son a menudo la fuente de nuestra agua potable […] Ya es la pandemia silenciosa. Se está convirtiendo en la próxima pandemia sin que realmente lo reconozcamos”, dijo a AFP Jonathan Cox, profesor de microbiología en la Universidad Aston de Reino Unido, que no participó del estudio de la ONU.
El documento completo está publicado en la página web del organismo.
Más contenido en Urgente24:
Atención: Nuevo requisito para viajar a destino del exterior
El alimento secreto que sirve para eliminar cucarachas
AFIP: ¿Qué pasa si pongo 1 millón de pesos en plazo fijo?